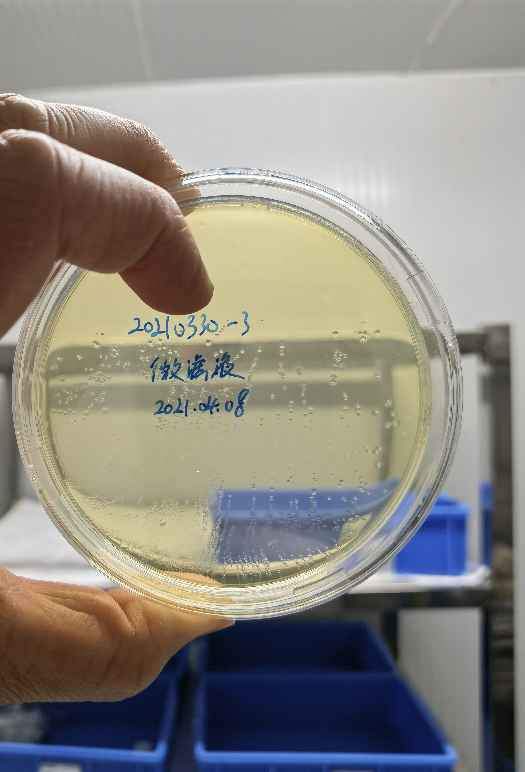

离心管内培养微生物
18811718979
请问各位大佬,如果我把微生物发酵液培养在2ml的扣盖离心管内,发酵液体积约为1mL,那么离心管内的环境还算是有氧环境吗?还是说我这么培养会导致细菌无氧发酵。不知道离心管盖子边缘是不是可以透气。
微生物
- 300
- 6
郑州大学 生物化工研究方向招聘在编教师和博士后
zhuangwei726
招聘单位:郑州大学化工学院生物化工团队招聘方向:合成生物学、生物化工等相关专业招生条件:(一)达到郑州大学人才引进要求,生物化工相关专业优先,对绿色生物制造有研究者优先;(二)具有生物、化学、生工、化工、材料等相关学科背景,并取得一定研究成果;(三)具有较强的...
微生物
- 1000
- 20

京公网安备 11010802022153号
京公网安备 11010802022153号